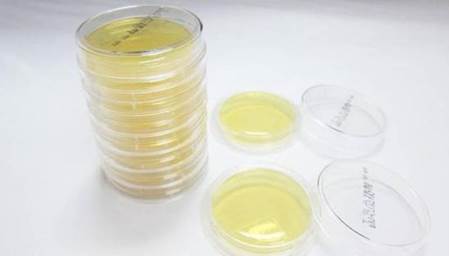
说明: C:\Users\hp\AppData\Local\Temp\WeChat Files\e05063b68101eb8e35d32e09e626d1cb.jpg

微生物日常检验过程中的注意事项
在微生物检验操作过程中,要保证检测环境(如超净台、检测室)以及所用工器具的洁净程度,同时保证人员各种操作的规范性,尽量保证其无菌性,防止因人为原因操作失误而出现误差结果,同时在适宜温度进行培养,为合理决策和指导生产提供依据。为保证检测结果的准确性,我们应做好以下几个方面:
培养基的灭菌及使用
1.每次配制时,要注意其生产日期是否在保质期内,查看其开瓶日期及瓶口密封性,保证其未变质,并且未吸潮。
2.培养基配制时,称量要准确,包括盐水的分装要准确。
3.一定要保证现配制现灭菌,未灭菌的配好培养基不能长时间放置,更不可隔夜。
4.灭菌时要保证恒温、恒压,同时要保证有效的灭菌时间。
5.灭菌过的培养基要冰箱保存,可保存一周,一般不超过 3 天。而且要遵循“先入先出”原则,先配制的要先使用。
6.在使用时,要根据当班次的使用量,用水浴锅先将培养基溶化为液态,然后及时调低水浴温度(先化好的可从水浴取出,放在水浴锅锅盖上)待用,千万不可长时间使培养基处于高温状态。
7.做产品微生物检测时,倾倒培养基温度在 45℃左右,不可过烫,避免将菌烫死;也不可过凉,化好的培养基又结块凝固,不便于观察结果。
8.每瓶培养基均要做空白。
9.尽量集中做样,避免频繁打开同一瓶培养基瓶塞,增大培养基的污染几率,出现误差结果。
10.培养基剩余过少时,可先将其倾倒成空白用板。
检测环境的维持
一、大环境(检测室)
1.检测时,窗户和空调要关闭,或用酒精对房间进行喷雾消毒,避免房间内空气流通影响超净台内部环境(***好在有通排风系统的恒温恒湿无菌间进行操作)。
2.如果在原来的原料微生物检测室进行检测,要定期开启紫外灯,对房间进行杀菌。
二、小环境(超净工作台)
1.定期清洁初效过滤器,要及时更换。
2.检测前,将超净台内部进行清洁,用 75%酒精进行擦拭消毒,并提前半小时将超净台紫外灯打开,对超净台内部环境进行杀菌。
3.关紫外灯,开风机,调整合适进风量,风量不可过低。
4.每次检测后,要对超净台内部进行清理、清洁,并用 75%酒精进行擦拭消毒。
5.紫外灯根据其使用寿命要及时更换。
6.检测同时,要做上相应菌落检测的环境空白。
7.检测区域的选择:
a、一般在距离超净台外沿的 1/3-2/3 区域进行无菌操作;
b、要在酒精灯火焰的外焰保护区域进行操作。

工器具的洁净度
1.玻璃器皿:采用干热灭菌方式进行灭菌。
2.检测用剪刀、勺子等物品要做到检测专用,不可与其它操作器具混用,使用时,先用75%酒精消毒,再采用灼烧方式进行灭菌。
3.接种针(环)采用灼烧方式进行灭菌,但要注意检测时要先将接种针(环)进行冷却。

样品的采集及检测
一、保证采样器具的无菌性
1.玻璃器皿:采用干热灭菌方式进行灭菌,保证恒温、时间足够(但不可时间过长,容易导致玻璃器皿易裂纹而报废)。
2.取样筐:使用前要用75%酒精进行喷洒消毒。
3.取样勺:要保证其清洁消毒,清洁后用75%酒精进行擦拭消毒。
4.取样袋:可先用酒精进行擦拭消毒,再在超净台用紫外灯照射消毒,(包装车间要在传递窗用紫外灯照射消毒)。
5.电子称表面用 75%酒精消毒。
二、人员操作
1.保证手部的清洗、消毒:取样前及检测前都要先洗手再消毒。
2.取样要具有代表性(随机样、目的样、综合样)且要标示清楚。
3.取样完毕,不可在车间逗留,要及时将样品放入超净台,对其外表面进行紫外灯照射消毒。
4.在要求的检测区域进行操作。
5.检测前,要用 75%酒精棉球对样品袋口部进行擦拭消毒,再开口。
6.往盐水瓶加样品时,要注意勺子或袋子尽量不接触瓶口。
7.样品计量要准确,稀释倍数也要准确(1mL 吸管不允许将管口敲掉),进行 100 倍稀释时,1mL 吸管要伸入盐水中,不可以将样品从管壁流下去,同时要避免将管底部捅破。
8.盐水温度以 40℃左右为宜,不能过热,会将部分微生物烫死;也不能温度太低,不能将样品溶解完全。
9.进行稀释时,要摇匀,保证溶液的均一性。
10.倾倒平皿时,要注意培养基瓶口不要接触到平皿;倾倒的培养基要适量,不可以太少,在培养过程中易干掉,微生物亦死亡,以 15mL 左右为宜。
11.做大肠菌群样时,要提前将乳糖胆盐培养基培养管按需要量备好,放入超净台对外表面进行紫外线灭菌。
12.接二步时,要注意先将接种针(环)进行冷却,避免出现接不上菌落的情况,导致无法判断、确认。
13.检测完毕,及时放入相应培养箱进行培养,并清理清洁超净台。

微生物的培养
1.在培养过程中,要随时监控培养箱温度,保证其在适宜的温度进行培养。
2.要按照《微生物检验规范》要求及时观察结果,出现异常,要及时分析原因进行反馈。
- 上一篇:微生物检测过程中操作问题与解答
- 下一篇:暂无

